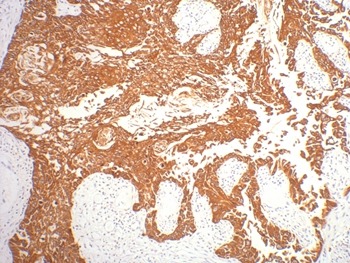

购物车
 您的购物车当前为空
您的购物车当前为空
Anti-KRT16 Antibody (5M214) 是一种 Mouse 抗体,靶向 KRT16。Anti-KRT16 Antibody (5M214) 可用于 IHC。
别名 type I cytoskeletal 16, KRT16A, KRT16, Keratin-16 (K16), Keratin, type I cytoskeletal 16, Cytokeratin-16 (CK-16)
Anti-KRT16 Antibody (5M214) 是一种 Mouse 抗体,靶向 KRT16。Anti-KRT16 Antibody (5M214) 可用于 IHC。
| 规格 | 价格 | 库存 | 数量 |
|---|---|---|---|
| 50 μL | ¥ 1,345 | 5日内发货 | |
| 100 μL | ¥ 2,195 | 5日内发货 |
TargetMol的所有产品仅用作科学研究或药证申报,不能被用于人体,我们不向个人提供产品和服务。请您遵守承诺用途,不得违反法律法规规定用于任何其他用途。
| 产品描述 | Anti-KRT16 Antibody (5M214) is a Mouse antibody targeting KRT16. Anti-KRT16 Antibody (5M214) can be used in IHC. |
| 别名 | type I cytoskeletal 16, KRT16A, KRT16, Keratin-16 (K16), Keratin, type I cytoskeletal 16, Cytokeratin-16 (CK-16) |
| 克隆号 | 5M214 |
| 反应种属 | Human,Mouse,Rat |
| 验证活性 | 1. IHC staining of human gullet cancer tissue with CK16 mouse mAb diluted at 1:200. |
| 应用 | IHC |
| 推荐剂量 | IHC: 1:200 |
| 抗体种类 | Monoclonal |
| 宿主来源 | Mouse |
| 构建方式 | Hybridoma Monoclonal Antibody |
| 纯化方式 | Affinity purification using immunogen. |
| 性状 | Liquid |
| 缓冲液 | Mouse IgG1 in phosphate buffered saline (without Mg2+ and Ca2+), pH 7.4, 150mM NaCl, 0.02% sodium azide and 50% glycerol. |
| 研究背景 | Keratin 16 is expressed in keratinocytes, which are undergoing rapid turnover in the suprabasal region (also known as hyperproliferation-related keratins). Keratin 16 is absent in normal breast tissue and in noninvasive breast carcinomas. Only 10% of the invasive breast carcinomas show diffuse or focal positivity. Reportedly, a relatively high concordance was found between the carcinomas immunostaining with the basal cell and the hyperproliferation-related keratins, but not between these markers and the proliferation marker Ki-67. This supports the conclusion that basal cells in breast cancer may show extensive proliferation, and that absence of Ki-67 staining does not mean that (tumor) cells are not proliferating. |
| 偶联 | Unconjugated |
| Uniprot ID |
| 分子量 | Actual: 51 kDa. |
| 储存方式 | Store at -20°C or -80°C for 12 months. Avoid repeated freeze-thaw cycles. |
| 运输方式 | Shipping with blue ice. |